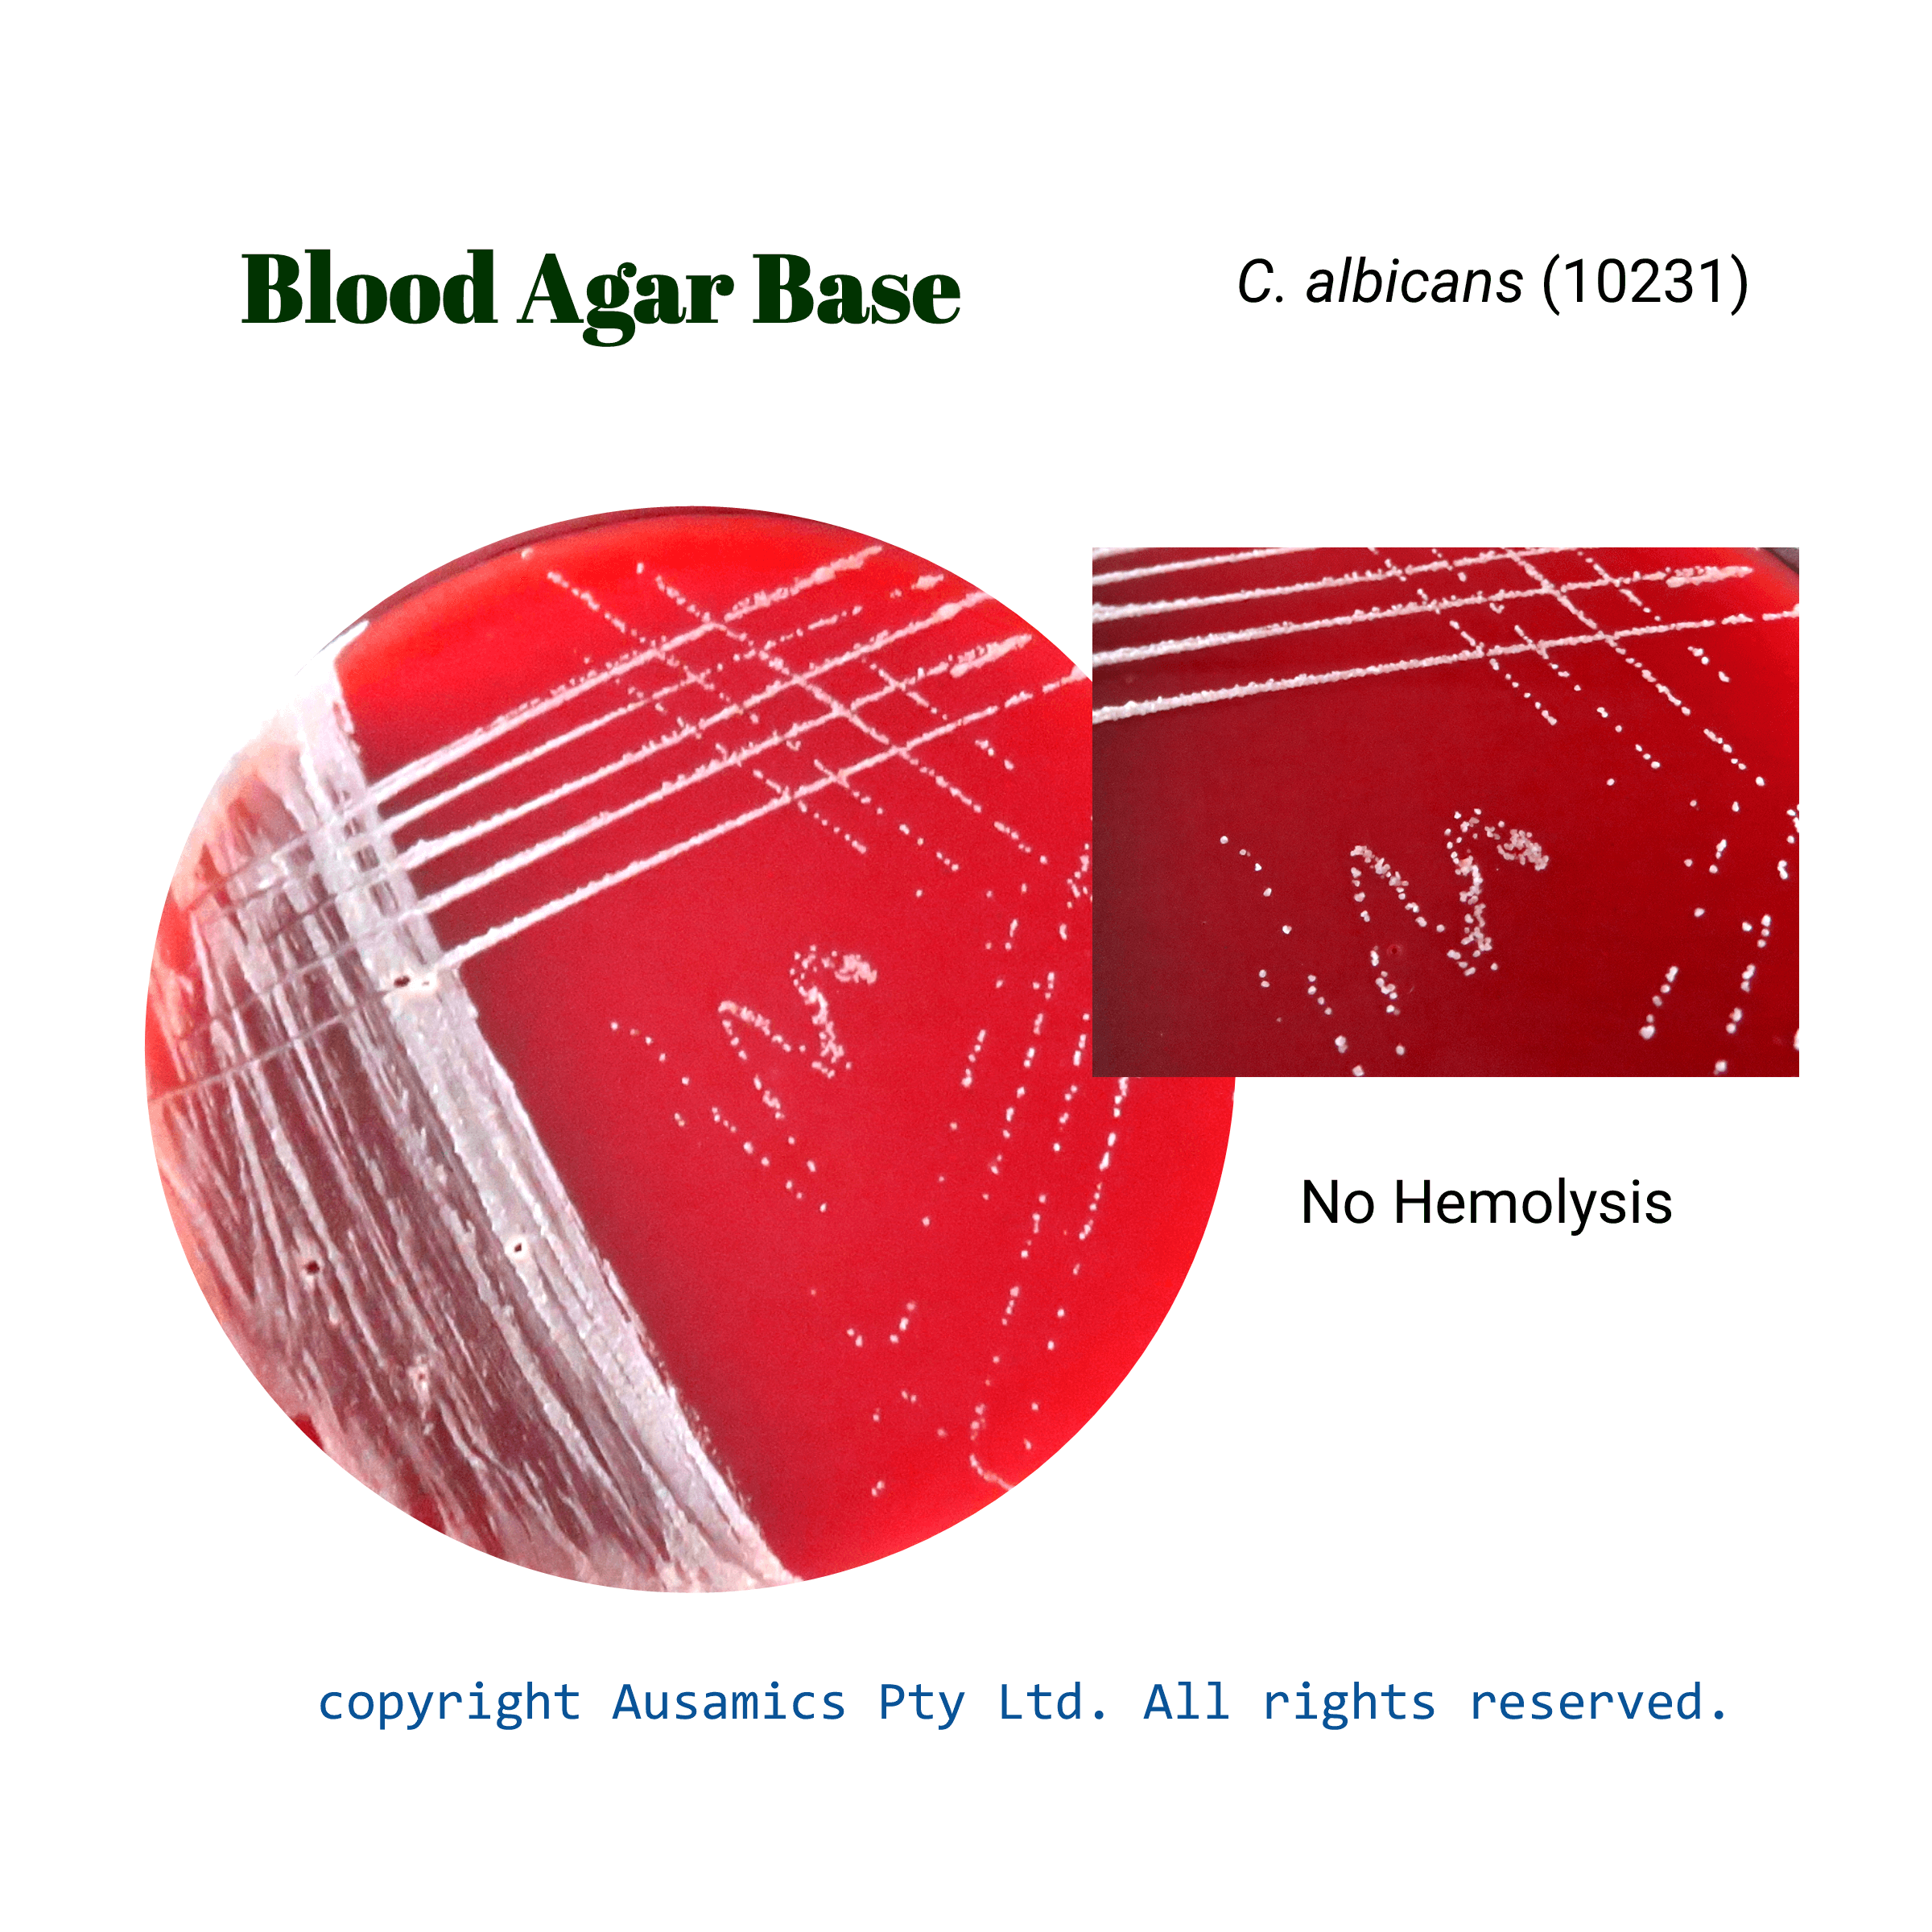
Blood_Agar_Base_Calbicans

Blood Agar Base
For preparing blood plates and boiled blood (Chocolate) plates used for the isolation and cultivation of various fastidious microorganisms, especially of pathogenic species, and for establishing their forms of hemolysis.
- Description
- Composition
- Quality Control
- Microbial Test Results
Blood Agar Base is a multipurpose culture medium that works well for a wide range of bacteria. It promotes distinct hemolysis zones when mixed with fresh, defibrinated sheep blood. Boiled blood can be added to make a nutrient-rich “chocolate agar.”
Peptones supply vital nutrients, and blood improves growth factors for fastidious organisms and facilitates the visualization of hemolytic reactions.
The blood type used can affect the result; for example, sheep blood works best against Group A Streptococci but is not appropriate for treating Haemophilus haemolyticus, which needs horse blood.
Storage
Keep the container at 15-30 °C and prepared medium at 2-8 °C.
| Composition | gr/L |
| Peptone Meat | 15 |
| Heart Extract | 5 |
| Sodium Chloride | 5 |
| Agar | 15 |
| Final pH at 25°C | 6.8 ± 0.2 |
| Dehydrated Appearance | Free flowing, homogeneous, beige |
| Prepared Appearance | Plain – Medium, yellow to tan, clear to slightly hazy. With 5% sheep blood – Cherry red, opaque. |
| Reaction of 4.0 % Solution at 25°C | pH 6.8 ± 0.2 |
| For 18 to 24 hours, incubate at 35 ± 2°C (Note that incubate streptococci with 3-5% CO2). | ||
| Organism (ATCC) | Recovery | Hemolysis |
| Escherichia coli (25922) | Good | Beta |
| Staphylococcus aureus (25923) | Good | Beta |
| Streptococcus pneumoniae (6305) | Good | Alpha |
| Candida albicans (10231) | Good | No Hemilysis |
| Pseudomonas aeruginosa (27853) | Good | N/A |